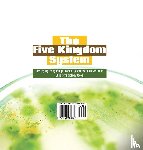

Stel een vraag
Ik heb een vraag over het boek:
‘The Five Kingdom System Classifying Living Things Book of Science for Kids 5th Grade Children's Biology Books - Baby Professor’.
Vul het onderstaande formulier in.
We zullen zo spoedig mogelijk antwoorden.